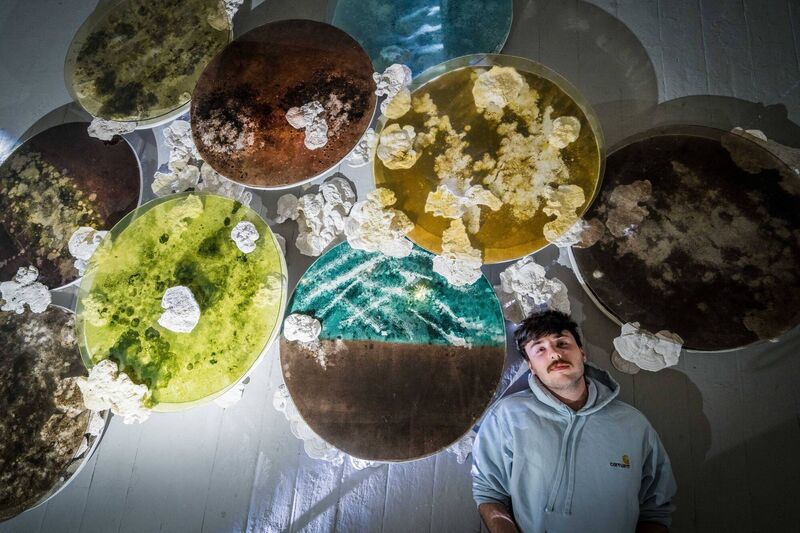
James Patrick Clancy, BA Fine Art student with his final year project at MTU Crawford College of Art and Design. Photo Joleen Cronin

Cork’s new crop of artists: Three Crawford graduates profiled
[ad_1]
Lest We Salt The Earth is the title of this year’s degree show for graduating students of MTU Crawford College of Art and Design’s BA in Fine Art, and BA in Contemporary Applied Art. As the name suggests, a concern with ecology and environment underpins a great many of the exhibited works.
Three profiles of graduating students from the BA in Fine Art represent these concerns here, but as ever, the degree show is rich with fresh approaches across both the Fine Art and Contemporary Applied Art class groups.
The exhibition of graduates’ work opens on Friday May 31 in MTU’s Sharman Crawford St campus and runs until June 6.
Leslie Allen Spillane’s Moments is a tender combination of analogue photography and printmaking that seeks to capture the essence of an elusive mother figure using techniques including pinhole photography and plant-based photographic chemicals.
In the centre of her exhibition space, she has placed a hardy little potted herb whose polyphenol compounds she has used in her process: Motherwort, a member of the mint family renowned for its properties in healing female complaints like period cramps and menopause symptoms.
“Motherwort is a symbol of healing, and I’m also using the plant as a kind of metaphor for the emotional themes of the work,” Allen Spillane says.
“The person I am photographing is kind of like a surrogate mother to me, so there’s an emotional connection to that person. I am exploring if it is possible to capture the essence of a person through photographic portraits. I spent eight or nine months photographing her.”
She lost her own mother, the artist Jo Allen – her father is Cork singer-songwriter John Spillane – tragically young, when Allen Spillane was just 14 years old. The subject of her photographs is her mother’s best friend, Sally, with whom she has remained close.
“It’s hard to know how personal you want to get with your work,” she says.” But I do feel it’s kind of like their essence is there, for me. Both of them.”

Allen Spillane’s final year thesis title was The Photographic Ecosystem: an investigation into the environmental impact of photography and the artists working towards a solution.
While all analogue photographers are aware that darkroom chemicals are hazardous to human health, Allen Spillane feels it’s time to centre an awareness that they are also environmental toxins: leftover darkroom chemicals require disposal as hazardous waste because they are as dangerous to other life forms as they are to humans.
“I’ve been trying to find more environmentally friendly ways of developing over the course of a couple of years,” she says. “I drew on the work of a group called The Sustainable Darkroom in the UK. Household items like Vitamin C powder and soda crystals, mixed with a tea made from plants, will develop your photos.” Plant chemicals produce less consistent outcomes than their toxic alternatives, but to Allen Spillane, factors like seasonality or residual staining of prints are a part of the magic: “the plant is a co-creator, like it’s a collaboration between me and the plants I am using,” she says.
Allen Spillane is a mature student, who did a Masters in Art History in UCC and then lived abroad for four years. She says moving into an art practice after years of academic theory has been a personal journey facilitated by the sense of community in art college.
“I have been creative my whole life, but in a little bubble by myself, so the sense of community has been amazing,” she says. “I think I learned more from my fellow students than from any teacher.”
James Patrick Clancy’s unique brand of bioart melds art and science to put our symbiotic relationships with micro-organisms quite literally under the microscope.
Clancy, from Conna in North Cork, worked in collaboration with the Department of Biological Sciences at MTU to culture microbes derived from soil samples taken at his home. The resulting patterns have been recreated under a series of petri-dish-like acrylic discs, displayed on the floor of the exhibition space and projected onto the wall. White casts of large bracket fungi bloom around their edges.
“This is all about the connection between fungi and bacteria in the soil and how it’s necessary to exist in collaborative states,” Clancy says.
Having read a paper by environmental philosopher Glenn Albrecht called “Exiting the Anthropocene and entering the Symbiocene,” Clancy decided to devote his degree show to the miracles of the subtle and endless dance of life that surrounds us, and what the human world can learn from symbiotic relationships found in nature.
For Clancy, these symbioses offer hope against a backdrop of relentlessly defeatist environmental messaging.
“Instead of just focusing on the harshness of the Anthropocene, the Symbiocene is a more optimistic approach to looking at the environmental crisis,” he says.
“I don’t want to hear about the apocalypse any more. We need to stop and look at ways to move forward. It’s about changing the viewpoint, and there are things all around us talking to each other and working together that we need to learn from.”
“I think we can figure it out, and I think art has a role in that.”
In fact, he views the collaboration between art and science represented in his work, titled Untitled: Clostridium of the Soil, as a kind of symbiosis in its own right.
Clancy went straight into his BA in Fine Arts after school, and he hopes to take a year out from studying before doing a Masters in Education to pursue his goal of secondary school teaching.
The common environmental theme that this year’s graduating students found in their work emerged organically, Clancy says, and is indicative of a broader generational shift in environmental awareness.
“When we looked at what we were doing, we discovered these main themes. Environment was evident in everyone’s work: it’s in the psyche now, and it’s not going to disappear. And that’s how it should be. People need to take this seriously.“
Although Lara Quinn’s Lillith doesn’t reflect directly on ecological themes, Quinn cites the 1970s goddess movement in feminist art, as well as Cuban-American performance artist Ana Mendieta’s use of materials like earth, sand and mud, as influences on her work.
Quinn, who grew up in Carrigaline and attended Coláiste Stíofáin Naofa before her BA in Fine Art at CCAD, has been inspired by the shadowy biblical mythology of Lillith, who in some Jewish traditions is depicted as Adam’s first wife, cast out of Eden for refusing to conform.
“She is given the choice to return to Eden, or to flee and be banished,” Quinn says. “She chooses the latter, and is condemned and demonised for it. I am very drawn to the trope of the fallen woman and goddess mythology. On top of that are themes of alienation, feelings of dysfunction and the inability to fit in. I feel a resonance with that in my own personal life.
“The concept is rooted in Jungian theory and the concept of self-mythology, so I am projecting myself upon a mythological figure to explore my experiences in life.” Three large and very beautiful oil paintings of the flame-haired Lillith draw unsettlingly on familiar iconography – Botticelli’s Venus is here, so is Síle-na-Gig – and are set in ornate frames inspired by ecclesiastical architecture and cave formations.
Pieces of text, Lillith’s origin story in the form of a poetic composition by Quinn, are etched into small metal plates in spiked frames.

In the centre of the exhibition space, a piece called Lillith’s Nest is comprised of moulded sand, set with small sculptural elements laden with symbolism: a cherubim’s sword, a looking glass, an egg containing a foetus. If there appears to be something devotional in this constellation of objects, it is by design: Quinn is, she says, “subverting the gallery space into a place of worship. I left my fingerprints as evidence that action was here, that there was touch involved in this act of devotion.”
Quinn says she approached her time at Crawford College of Art and Design with some trepidation, fearing she wouldn’t last a year.
“I remember thinking, ‘I am probably going to drop out within a year, it probably won’t be for me,’” she says. “But that first year flew by. I never want to stop making art. For me now, it’s about trying to make it become my life. The whole time here has been one of the most fulfilling experiences ever.”
[ad_2]
Source link







No Comment! Be the first one.